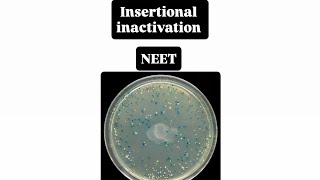
Insertional inactivation  NEET biotech class 12

- Популярные видео
- Авто
- Видео-блоги
- ДТП, аварии
- Для маленьких
- Еда, напитки
- Животные
- Закон и право
- Знаменитости
- Игры
- Искусство
- Комедии
- Красота, мода
- Кулинария, рецепты
- Люди
- Мото
- Музыка
- Мультфильмы
- Наука, технологии
- Новости
- Образование
- Политика
- Праздники
- Приколы
- Природа
- Происшествия
- Путешествия
- Развлечения
- Ржач
- Семья
- Сериалы
- Спорт
- Стиль жизни
- ТВ передачи
- Танцы
- Технологии
- Товары
- Ужасы
- Фильмы
- Шоу-бизнес
- Юмор
Видео Youtube, insertion inactivation
30 марта 2026 г. 12:30:00 The VicharPath Жалоба на материал Недопустимый материал Нарушение авторских прав
10 февраля 2026 г. 16:03:31 Neet concepts Жалоба на материал Недопустимый материал Нарушение авторских прав
4 февраля 2026 г. 9:30:39 NCERT NEET Adda247 Жалоба на материал Недопустимый материал Нарушение авторских прав
1 ноября 2025 г. 15:04:41 Neetport Жалоба на материал Недопустимый материал Нарушение авторских прав
Insertional Insertional Inactivation: A Smart Strategy to Identify Transformants!#ctet #htet #dsssb#
4 апреля 2025 г. 7:30:20 Bio Innovate Academy Жалоба на материал Недопустимый материал Нарушение авторских прав
INSERTIONAL INACTIVATION #biotechnology #Genetic Engineering#PUC8 VECTOR #PLASMID#BIOBYTTES#NEET#ISC
9 февраля 2025 г. 18:15:31 BIO BYTTES Жалоба на материал Недопустимый материал Нарушение авторских прав
Insertion|Replacement Vector|λZAPII|λgt10|λEMBL4|Blue-white screening|Insertion inactivation|بالعربي
30 декабря 2024 г. 1:31:40 كروموسوم.Chromosome Жалоба на материал Недопустимый материал Нарушение авторских прав
4 ноября 2024 г. 20:20:22 | BIO-TERRITORY | DHRUV RIKHARI Жалоба на материал Недопустимый материал Нарушение авторских прав
8 октября 2024 г. 18:00:55 Xylem Plus Two NEET / JEE Жалоба на материал Недопустимый материал Нарушение авторских прав
17 сентября 2024 г. 20:26:17 Nitin Biology Жалоба на материал Недопустимый материал Нарушение авторских прав
14 августа 2024 г. 6:30:08 BioTanime23 Жалоба на материал Недопустимый материал Нарушение авторских прав
INSERTIONAL INACTIVATION CLASS 12 RAPID REVISION | HUMAN HEALTH AND DISEASES NEET 2024 BY BHARTI MAM
3 мая 2024 г. 22:30:05 Doctor's Adda247 Жалоба на материал Недопустимый материал Нарушение авторских прав
31 января 2024 г. 15:08:46 C.M. Abhyudaya Basti Жалоба на материал Недопустимый материал Нарушение авторских прав
A Recombinant DNA is Inserted Within The Coding Sequence | QuickShot Biology | #biology #cuet #ncert
1 января 2024 г. 16:45:03 CUET Competishun Жалоба на материал Недопустимый материал Нарушение авторских прав
30 декабря 2023 г. 8:13:04 Hilal Sir's Biology Жалоба на материал Недопустимый материал Нарушение авторских прав
30 декабря 2023 г. 8:09:03 Hilal Sir's Biology Жалоба на материал Недопустимый материал Нарушение авторских прав
5 декабря 2023 г. 18:36:52 Tanuja Biostudies Жалоба на материал Недопустимый материал Нарушение авторских прав
7 марта 2023 г. 13:55:01 Dr. Asif Academy Жалоба на материал Недопустимый материал Нарушение авторских прав
3 января 2023 г. 20:22:27 Dr. LR Yadav (Ph.D. Zoology) Жалоба на материал Недопустимый материал Нарушение авторских прав
20 декабря 2022 г. 20:26:57 Examपुर UP Board Жалоба на материал Недопустимый материал Нарушение авторских прав
15 ноября 2022 г. 2:11:30 PW Solutions Жалоба на материал Недопустимый материал Нарушение авторских прав
In insertional inactivation, the recombinant DNA is inserted within the coding sequence of (a) β-...
17 октября 2022 г. 18:07:26 PW Solutions Жалоба на материал Недопустимый материал Нарушение авторских прав
13 октября 2022 г. 10:08:16 Dr. PREM-PRIMER Biotech Lectures Жалоба на материал Недопустимый материал Нарушение авторских прав
31 августа 2022 г. 21:24:20 Mastery with Parul Жалоба на материал Недопустимый материал Нарушение авторских прав
13 августа 2022 г. 15:02:46 Sumo Biology Shorts Жалоба на материал Недопустимый материал Нарушение авторских прав
13 августа 2022 г. 14:23:38 Sumo “Sumesh Monga” Biology Жалоба на материал Недопустимый материал Нарушение авторских прав
In the process of insertional inactivation (a) a recombinant DNA is inserted within the coding se...
30 июля 2022 г. 17:47:06 PW Solutions Жалоба на материал Недопустимый материал Нарушение авторских прав
29 января 2022 г. 14:30:40 Biology2Minutes Жалоба на материал Недопустимый материал Нарушение авторских прав
19 января 2022 г. 1:43:08 SEEMA ATREJA Жалоба на материал Недопустимый материал Нарушение авторских прав
10 января 2022 г. 17:36:42 RBC (Radhika Biology Classes) Жалоба на материал Недопустимый материал Нарушение авторских прав
9 января 2022 г. 7:29:09 Bio by RC Жалоба на материал Недопустимый материал Нарушение авторских прав
26 декабря 2021 г. 11:35:26 Ashokkumar kumar Жалоба на материал Недопустимый материал Нарушение авторских прав